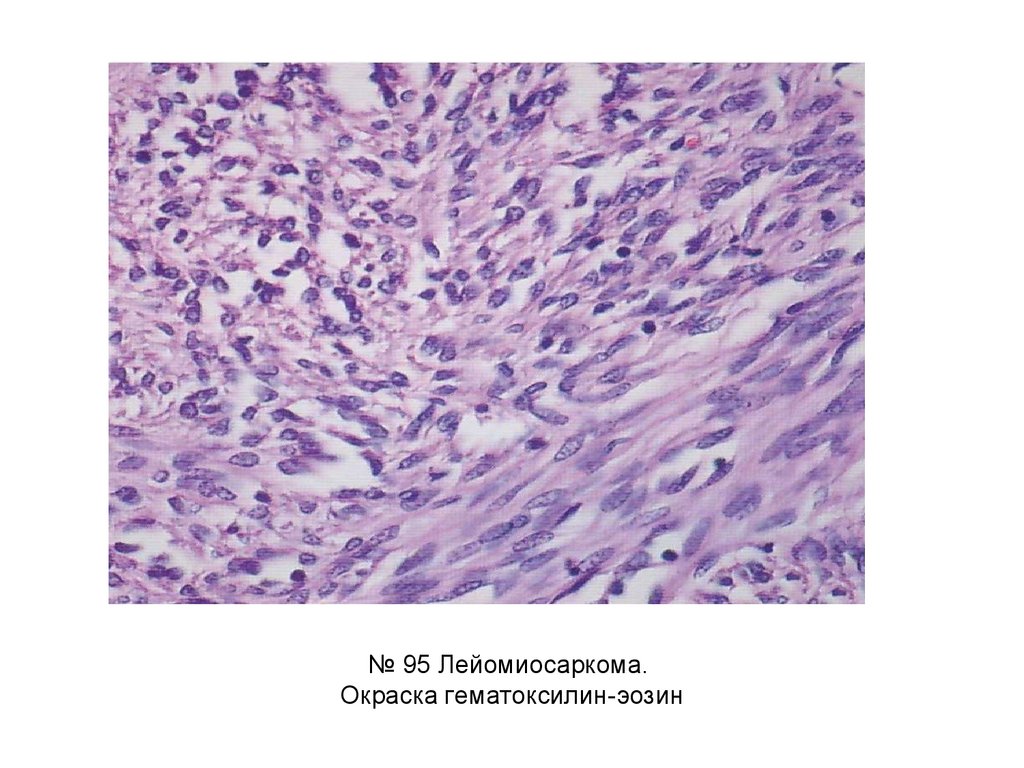

Похожие презентации:
Мезенхимальные опухоли
1.
Опухоли. Общие положения.Опухоли из мезенхимальных
тканей. Опухоли из
меланинобразующей ткани
2.
№ 41 Фиброма кожи.Окраска гематоксилин-эозин.
3.
№ 41 Фиброма кожи.Окраска гематоксилин-эозин.
4.
№ 41 Фиброма кожи.Окраска гематоксилин-эозин.
5.
Хаотичное расположение пучковволокон (проявление тканевого
атипизма)
№ 41 Фиброма кожи.
Окраска гематоксилин-эозин.
6.
№ 50 Фибромиома матки.Окраска по Ван-Гизон.
7.
Соединительнаяткань — красного
цвета
Гладкомышечная —
желто-зеленая
Ядра - коричнево черные
Проявление тканевого атипизма:
-хаотичное расположение пучков волокон,
-неравномерное расположение
соединительнотканных частей гладкомышечной
ткани
№ 50 Фибромиома матки.
Окраска по Ван-Гизон.
8.
№ 49 Хондрома.Окраска гематоксилин-эозин.
9.
№ 49 Хондрома.Окраска гематоксилин-эозин.
10.
Неравномерное расположение зрелых клетоктипа хондроцитов в межуточной ткани («где
густо, где пусто»)
№ 49 Хондрома.
Окраска гематоксилин-эозин.
11.
№ 51 Кавернозная гемангиома печени.Окраска гематоксилин-эозин.
12.
32
Опухоль состоит из сосудов, варьирующих по форме и размеру, с широкими
просветами, заполненными кровью (1).
Выстилка — зрелый эндотелий (2). Четкие границы с печеночной тканью (3).
1
№ 51 Кавернозная гемангиома печени.
Окраска гематоксилин-эозин.
13.
№ 55 Низкодифференцированная фибросаркома.Окраска гематоксилин-эозин
14.
Резко выражен клеточныйатипизм, мало коллагеновых
волокон (т.к клетки утратили
способность его вырабатывать)
№ 55 Низкодифференцированная фибросаркома. Окраска гематоксилин-эозин
15.
№ 78 Хондросаркома.Окраска гематоксилинэозин
16.
№ 78 Хондросаркома.Окраска гематоксилинэозин
17.
№ 78 Хондросаркома. Окраска гематоксилин-эозин18.
№ 95 Лейомиосаркома.Окраска гематоксилин-эозин
19.
№ 95 Лейомиосаркома.Окраска гематоксилин-эозин
20.
№ 57 Меланома.Окраска гематоксилин-эозин
21.
№ 57 Меланома.Окраска гематоксилин-эозин
22.
Описание макропрепаратов1)Фибромиома матки
Матка в размере увеличена, деформирована, на разрезе в миометрии
множественные узлы округлой формы плотной консистенции
белесоватого цвета.
2)Хондрома пальца
Палец деформирован, утолщен, на разрезе новообразования
овальной или округлой формы, консистенция хрящевой плотности,
белесоватого цвета на разрезе.

Медицина
Медицина








